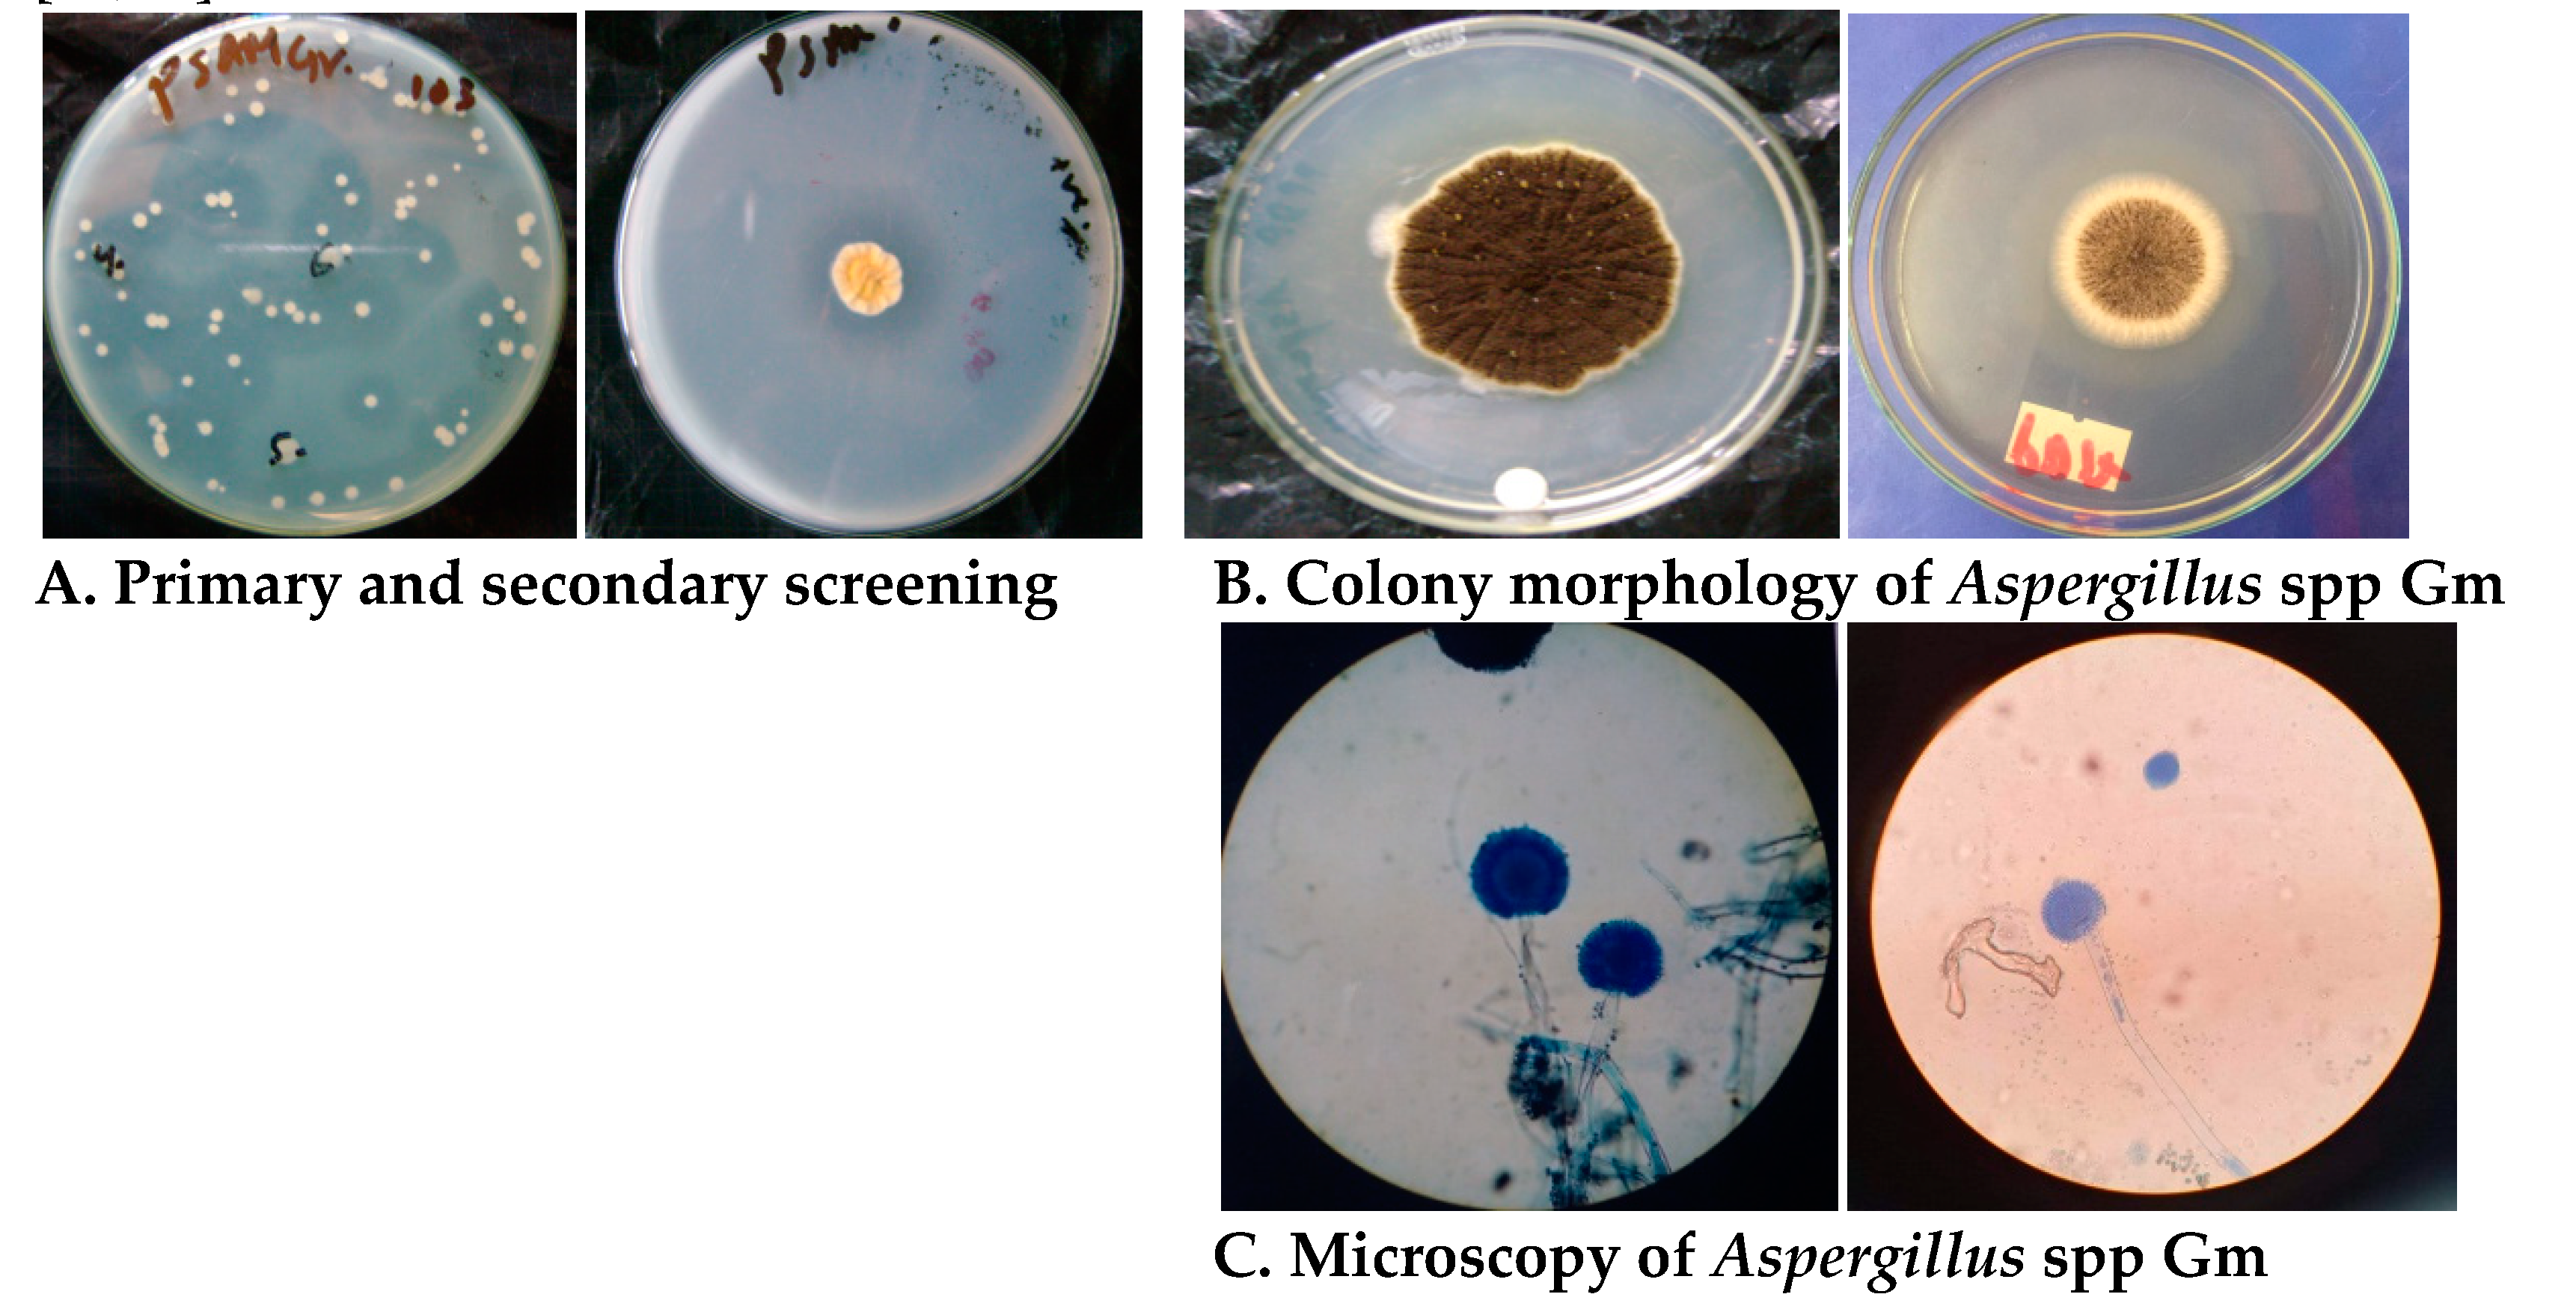
Fermentation 06 00059 g001

Production, Characterization, and Industrial Application of Pectinase Enzyme Isolated from Fungal Strains
Abstract
1. Introduction
2. Materials and Methods
2.1. Soil Sampling
2.2. Isolation, Screening, and Identification of Pectinolytic Fungi
2.3. Enzyme Production
2.3.1. Submerged Fermentation for Enzyme Production
2.3.2. Effect of Various Factors on Enzyme Production
2.3.3. Enzyme Extraction and Partial Purification
2.4. Characterization of Partially Purified Pectinase Enzyme
2.4.1. Thermal Stability
2.4.2. Effect of Temperature on Enzyme Activity
2.4.3. Effect of pH on Enzyme Activity
2.4.4. Effect of Substrate Concentration on Enzyme Activity
2.5. Application of Pectinase Enzyme
2.6. Statistical Analysis
3. Results and Discussion
3.1. Isolation, Screening, and Identification of the Fungal Isolates
3.2. Optimization of the Fermentation Conditions for Maximum Enzyme Production
3.3. Characteristics of Partially Purified Pectinase
3.4. Application of Pectinase Enzyme in Juice Clarification
4. Conclusions
Author Contributions
Funding
Acknowledgments
Conflicts of Interest
References
- Kavuthodi, B.; Sebastian, D. Review on bacterial production of alkaline pectinase with special emphasis on Bacillus species. Biosci. Biotechnol. Res. Commun. 2018, 11, 18–30. [Google Scholar] [CrossRef]
- Alkorta, I.; Garbisu, C.; Llama, M.J.; Serra, J.L. Industrial applications of pectic enzymes: A review. Process Biochem. 1998, 33, 21–28. [Google Scholar] [CrossRef]
- Javed, R.; Nawaz, A.; Munir, M.; Hanif, M.; Mukhtar, H.; Haq, I.U.; Abdullah, R. Extraction, purification and industrial applications of pectinase: A review. J. Biotechnol. Biores. 2018, 1, 1–6. [Google Scholar]
- Carrasco, M.; Rozas, J.M.; Alcaíno, J.; Cifuentes, V.; Baeza, M. Pectinase secreted by psychrotolerant fungi: Identification, molecular characterization and heterologous expression of a cold-active polygalacturonase from Tetracladium sp. Microb. Cell Fact. 2019, 18, 45. [Google Scholar] [CrossRef]
- Cornuault, V.; Posé, S.; Knox, J.P. Disentangling pectic homogalacturonan and rhamnogalacturonan-I polysaccharides: Evidence for sub-populations in fruit parenchyma systems. Food Chem. 2018, 246, 275–285. [Google Scholar] [CrossRef] [PubMed]
- Pedrolli, D.B.; Monteiro, A.C.; Gomes, E.; Carmona, E.C. Pectin and pectinases: Production, characterization and industrial application of microbial pectinolytic enzymes. Open Biotechnol. J. 2009, 3, 9–18. [Google Scholar] [CrossRef]
- Oumer, O.J.; Abate, D. Screening and molecular identification of pectinase producing microbes from coffee pulp. Biomed Res. Int. 2018, 2018, 2961767. [Google Scholar] [CrossRef]
- Garg, G.; Singh, A.; Kaur, A.; Singh, R.; Kaur, K.; Mahajan, R. Microbial pectinases: An ecofriendly tool of nature for industries. Biotech 2016, 6, 1–13. [Google Scholar] [CrossRef]
- Oumer, O.J. Pectinase: Substrate, production and their biotechnological applications. Int. J. Environ. Agric. Biotechnol. 2017, 2, 1007–1014. [Google Scholar] [CrossRef]
- Gummadi, S.N.; Panda, T. Purification and biochemical properties of microbial pectinases—A review. Process Biochem. 2003, 38, 987–996. [Google Scholar] [CrossRef]
- Hoondal, G.; Tiwari, R.; Tewari, R.; Dahiya, N.; Beg, Q. Microbial alkaline pectinases and their industrial applications: A review. Appl. Microbiol. Biotechnol. 2002, 59, 409–418. [Google Scholar] [PubMed]
- Khairnar, Y.; Krishna, V.K.; Boraste, A.; Gupta, N.; Trivedi, S.; Patil, P.; Gupta, G.; Gupta, M.; Jhadav, A.; Mujapara, A.; et al. Study of pectinase production in submerged fermentation using different strains of Aspergillus Niger. Int. J. Microbiol. Res. 2009, 1, 13–17. [Google Scholar] [CrossRef]
- Dhital, R.; Panta, O.P.; Karki, T.B. Optimization of cultural conditions for the production of pectinase from selected fungal strain. J. Food Sci. Technol. Nepal 2014, 8, 65–70. [Google Scholar] [CrossRef]
- Barman, S.; Sit, N.; Badwaik, L.S.; Deka, S.C. Pectinase production by Aspergillus niger using banana (Musa balbisiana) peel as substrate and its effect on clarification of banana juice. J. Food Sci. Technol. 2015, 52, 3579–3589. [Google Scholar] [CrossRef] [PubMed][Green Version]
- Kubra, K.T.; Ali, S.; Walait, M.; Sundus, H. Potential applications of pectinases in food, agricultural and environmental sectors. J. Pharm. Chem. Biol. Sci. 2018, 6, 23–34. [Google Scholar]
- Koirala, N.; Pandey, R.P.; Parajuli, P.; Jung, H.J.; Sohng, J.K. Methylation and subsequent glycosylation of 7,8-dihydroxyflavone. J. Biotech. 2014, 184, 128–137. [Google Scholar] [CrossRef] [PubMed]
- Patidar, M.K.; Nighojkar, S.; Kumar, A.; Nighojkar, A. Pectinolytic enzymes-solid state fermentation, assay methods and applications in fruit juice industries: A review. 3 Biotech 2018, 8, 199. [Google Scholar] [CrossRef]
- Kim, J.Y.; Lee, S.Y.; Choi, H.S. Molecular and morphological identification of fungal species isolated from rice meju. Food Sci. Biotechnol. 2013, 22, 721–728. [Google Scholar] [CrossRef]
- Lu, Y.; Chen, C.; Chen, H.; Zhang, J.; Chen, W. Isolation and identification of endophytic fungi from Actinidia macrosperma and investigation of their bioactivities. Evid. -Based Complement. Altern. Med. 2012, 2012, 382742. [Google Scholar] [CrossRef][Green Version]
- Hankin, L.; Anagnostakis, S.L. The use of solid media for detection of enzyme production by fungi. Mycologia 1975, 67, 597–607. [Google Scholar] [CrossRef]
- Kashyap, D.R.; Chandra, S.; Kaul, A.; Tewari, R. Production, purification and characterization of pectinase from a Bacillus sp. DT7. World J. Microbiol. Biotechnol. 2000, 16, 277–282. [Google Scholar] [CrossRef]
- Miller, G.L. Use of dinitrosalicylic acid reagent for determination of reducing sugar. Anal. Chem. 1959, 31, 426–428. [Google Scholar] [CrossRef]
- Rajendran, R.; Karthik, S.; Radhai, R.; Rajapriya, P.; Balakumar, C. Production and optimization of fungal pectinase from Fusarium sp. Int. J. Curr. Res. 2011, 3, 254–258. [Google Scholar]
- Arotupin, D.J.; Akinyosoye, F.A.; Onifade, A.K. Purification and characterization of pectinmethylesterase from Aspergillus repens isolated from cultivated soil. Afr. J. Biotechnol. 2008, 7, 1991–1998. [Google Scholar] [CrossRef]
- Maciel, M.; Herculano, P.; Porto, T.; Teixeira, M.; Moreira, K.; De Souza-Motta, C. Production and partial characterization of pectinases from forage palm by Aspergillus niger URM4645. Afr. J. Biotechnol. 2011, 10, 2469–2475. [Google Scholar]
- Rai, P.; Majumdar, G.C.; DasGupta, S.; De, S. Optimizing pectinase usage in pretreatment of mosambi juice for clarification by response surface methodology. J. Food Eng. 2004, 64, 397–403. [Google Scholar] [CrossRef]
- Abdullah, R.; Farooq, I.; Kaleem, A.; Iqtedar, M.; Iftikhar, T. Pectinase production from Aspergillus niger IBT-7 using solid state fermentation. Bangladesh J. Bot. 2018, 47, 473–478. [Google Scholar] [CrossRef]
- Rashmi, R.; Murthy, K.; Sneha, G.; Shabana, S.; Syama, A.; Radhika, V. Partial purification and biochemical characterization of extracellular pectinase from Aspergillus niger isolated from groundnut seeds. J. Appl. Biosci. 2008, 9, 378–384. [Google Scholar]
- Phutela, U.; Dhuna, V.; Sandhu, S.; Chadha, B.S. Pectinase and polygalacturonase production by a thermophilic Aspergillus fumigatus isolated from decomposting orange peels. Braz. J. Microbiol. 2005, 36, 63–69. [Google Scholar] [CrossRef]
- Biz, A.; Farias, F.C.; Motter, F.A.; De Paula, D.H.; Richard, P.; Krieger, N.; Mitchell, D.A. Pectinase activity determination: An early deceleration in the release of reducing sugars throws a spanner in the works. PLoS ONE 2014, 9, e109529. [Google Scholar] [CrossRef]
- Patil, N.P.; Chaudhari, B.L. Production and purification of pectinase by soil isolate Penicillium spp and search for better agro-residue for its SSF. Recent Res. Sci. Technol. 2010, 2, 36–42. [Google Scholar]
- Palaniyappan, M.; Vijayagopal, V.; Viswanathan, R.; Viruthagiri, T. Screening of natural substrates and optimization of operating variables on the production of pectinase by submerged fermentation using Aspergillus niger MTCC 281. Afr. J. Biotechnol. 2009, 8, 682–686. [Google Scholar]
- Akhter, N.; Morshed, M.A.; Uddin, A.; Begum, F.; Sultan, T.; Azad, A.K. Production of pectinase by Aspergillus niger cultured in solid state media. Int. J. Biosci. 2011, 1, 33–42. [Google Scholar]
- Al-Najada, A.R.; Al-Hindi, R.R.; Mohamed, S.A. Characterization of polygalacturonases from fruit spoilage Fusarium oxysporum and Aspergillus tubingensis. Afr. J. Biotechnol. 2012, 11, 8527–8536. [Google Scholar] [CrossRef]
- Singh, S.; Mandal, S.K. Optimization of processing parameters for production of pectinolytic enzymes from fermented pineapple residue of mixed Aspergillus species. Jordan J. Biol. Sci. 2012, 5, 307–314. [Google Scholar]
- Khatri, B.P.; Bhattarai, T.; Shrestha, S.; Maharjan, J. Alkaline thermostable pectinase enzyme from Aspergillus niger strain MCAS2 isolated from Manaslu Conservation Area, Gorkha, Nepal. Springerplus 2015, 4, 488. [Google Scholar] [CrossRef]
- Deshmukh, N.; Talkal, R.; Jha, K.; Singh, P.G.; Prajapati, D.C. Production, purification, characterization and comparison of polygalacturonase from various strains of Aspergillus. Int. J. Sci. Technol. Res. 2012, 1, 85–91. [Google Scholar]
- Dogan, N.; Tari, C. Characterization of three-phase partitioned exo-polygalacturonase from Aspergillus sojae with unique properties. Biochem. Eng. J. 2008, 39, 43–50. [Google Scholar] [CrossRef]
- Martins, E.S.; Silva, D.; Da Silva, R.; Gomes, E. Solid state production of thermostable pectinases from thermophilic Thermoascus aurantiacus. Process Biochem. 2002, 37, 949–954. [Google Scholar] [CrossRef]
- Mohamed, S.A.; Al-Malki, A.L.; Kumosani, T.A. Characterization of a polygalacturonase from Trichoderma harzianum grown on citrus peel with application for apple Juice. Aust. J. Basic Appl. Sci. 2009, 3, 2770–2777. [Google Scholar]
- Jayani, R.S.; Saxena, S.; Gupta, R. Microbial pectinolytic enzymes: A review. Process Biochem. 2005, 40, 2931–2944. [Google Scholar] [CrossRef]
- Ferreira, V.; da Silva, R.; Silva, D.; Gomes, E. Production of pectate lyase by Penicillium viridicatum RFC3 in solid-state and submerged fermentation. Int. J. Microbiol. 2010, 1–8. [Google Scholar] [CrossRef]
- Sandri, I.; Silveira, M. Production and application of pectinases from Aspergillus niger obtained in solid state cultivation. Beverages 2018, 4, 48. [Google Scholar] [CrossRef]
- Demir, H.; Tari, C. Valorization of wheat bran for the production of polygalacturonase in SSF of Aspergillus sojae. Ind. Crops Prod. 2014, 54, 302–309. [Google Scholar] [CrossRef]
- Kareem, S.; Adebowale, A. Clarification of orange juice by crude fungal pectinase from citrus peel. Niger. Food J. 2007, 25, 130–137. [Google Scholar] [CrossRef][Green Version]
- Joshi, V.; Parmar, M.; Rana, N. Purification and characterization of pectinase produced from apple pomace and evaluation of its efficacy in fruit juice extraction and clarification. Indian J. Nat. Prod. Resour. 2011, 2, 189–197. [Google Scholar]

| Enzyme Concentration (%) | Yield | Total Soluble Solids (TSS) | Absorbance at 540 nm | % Transmittance | ||
|---|---|---|---|---|---|---|
| Initial Volume (mL) | Final Volume (mL) | Initial (°Brix) | Final (°Brix) | |||
| 0 | 20.0 | 20.0 | 6.0 | 6.0 | 0.0 | 10.0 |
| 0.25 | 20.0 | 20.2 | 5.0 | 5.5 | 0.48 | 13.0 |
| 0.5 | 20.0 | 20.5 | 5.0 | 5.5 | 0.66 | 17.9 |
| 0.75 | 20.0 | 21.0 | 5.0 | 6.0 | 0.70 | 19.6 |
| 1.0 | 20.0 | 21.7 | 5.0 | 7.0 | 0.75 | 21.0 |
© 2020 by the authors. Licensee MDPI, Basel, Switzerland. This article is an open access article distributed under the terms and conditions of the Creative Commons Attribution (CC BY) license (http://creativecommons.org/licenses/by/4.0/).
Share and Cite
KC, S.; Upadhyaya, J.; Joshi, D.R.; Lekhak, B.; Kumar Chaudhary, D.; Raj Pant, B.; Raj Bajgai, T.; Dhital, R.; Khanal, S.; Koirala, N.; et al. Production, Characterization, and Industrial Application of Pectinase Enzyme Isolated from Fungal Strains. Fermentation 2020, 6, 59. https://doi.org/10.3390/fermentation6020059
KC S, Upadhyaya J, Joshi DR, Lekhak B, Kumar Chaudhary D, Raj Pant B, Raj Bajgai T, Dhital R, Khanal S, Koirala N, et al. Production, Characterization, and Industrial Application of Pectinase Enzyme Isolated from Fungal Strains. Fermentation. 2020; 6(2):59. https://doi.org/10.3390/fermentation6020059
Chicago/Turabian StyleKC, Sudeep, Jitendra Upadhyaya, Dev Raj Joshi, Binod Lekhak, Dhiraj Kumar Chaudhary, Bhoj Raj Pant, Tirtha Raj Bajgai, Rajiv Dhital, Santosh Khanal, Niranjan Koirala, and et al. 2020. "Production, Characterization, and Industrial Application of Pectinase Enzyme Isolated from Fungal Strains" Fermentation 6, no. 2: 59. https://doi.org/10.3390/fermentation6020059
APA StyleKC, S., Upadhyaya, J., Joshi, D. R., Lekhak, B., Kumar Chaudhary, D., Raj Pant, B., Raj Bajgai, T., Dhital, R., Khanal, S., Koirala, N., & Raghavan, V. (2020). Production, Characterization, and Industrial Application of Pectinase Enzyme Isolated from Fungal Strains. Fermentation, 6(2), 59. https://doi.org/10.3390/fermentation6020059

